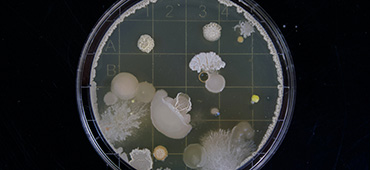
microbioom

MS en het mediterraan dieet

![]() Leefstijl • Artikel
Leefstijl • Artikel
Steeds meer onderzoek wijst erop dat het mediterraan dieet positief kan werken voor mensen met MS. Maar waar bestaat dit dieet uit? En welke effecten kan het dan hebben op jouw kwaliteit van leven? In dit artikel vertellen we je er meer over.
Hoewel er steeds meer onderzoek gedaan wordt naar multiple sclerose en voeding, is er geen ‘wonderdieet’ dat al je MS-symptomen als sneeuw voor de zon doet verdwijnen. Wel lijken verschillende diëten mogelijk voordelen te bieden. Het mediterraan dieet is er daar een van.
Waar bestaat het mediterraan dieet uit?
Het mediterraan dieet is gebaseerd op de traditionele keuken van landen rond de Middellandse Zee, zoals Frankrijk, Griekenland, Italië, Portugal en Spanje. Hier wordt van oudsher veel volkorenproducten gegeten, groenten, fruit, peulvruchten (zoals bonen, erwten, linzen en pinda’s), olijfolie en vis. Ze zijn matig met het consumeren van boter en andere dierlijke vetten (verzadigde vetten), rood vlees, gevogelte en zuivelproducten. Bij de maaltijden wordt met mate rode wijn gedronken.
De effecten van het mediterraan dieet bij MS
In 2023 deed een groep wetenschappers onderzoek naar de invloed van het mediterraan dieet op mensen met MS. Ze analyseerden meerdere studies die naar dit onderwerp gedaan zijn. Hieruit bleek dat het mediterraan dieet een positief effect heeft op de aanwezigheid van ontstekingen en op MS-symptomen zoals fatigue (extreme vermoeidheid) en cognitieve problemen (zoals geheugen en concentratie). Het dieet zou voor een betere kwaliteit van leven kunnen zorgen en de kans op schubs verkleinen.
Wel benadrukten de wetenschappers dat er meer onderzoek nodig is om met zekerheid vast te stellen wat de positieve invloed van het mediterraan dieet bij mensen met MS is. Vaststaat is dat het mediterraan dieet een gezonde manier van eten is, ook voor mensen die geen MS hebben.
Wat kun jij doen?
Wil jij weten hoe je het mediterraan dieet in je eigen leven kunt inpassen? Een in MS-gespecialiseerde diëtist kan je daarbij helpen. Op de website van MS Zorg Nederland kun je kijken of er een MS-diëtist bij jou in de buurt zit. Ook zijn er veel kookboeken geschreven die je kunnen helpen je voedingspatroon aan te passen.
- Mediterranean-like diets in multiple sclerosis: A systematic review – ScienceDirect, 17 juli 2023. Laatst bekeken maart 2025
- Mediterranean Diet and MS – Multiple Sclerosis News Today. Laatst bekeken maart 2025
MAT-NL-2500226v1-042025